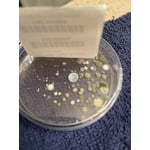
Image 4 of customer photos

Hero image 0 of MOLD ARMOR Do-It-Yourself Mold Detection Test Kit, 0 of 7
Overall pick
MOLD ARMOR Do-It-Yourself Mold Detection Test Kit
Current price is USD$11.97
Price when purchased online
- Free 90-day returns
How do you want your item?
Try 30 days of Free Shipping with Walmart+! Choose plan at checkout.
Columbus, 43215
Arrives by Tue, Mar 24
Only 8 left
Sold and shipped by Walmart.com
Free 90-day returns
This item is gift eligible
Get free delivery, shipping and more*
*Restrictions apply
About this item
Customer ratings & reviews
4.2 out of 5 stars
How item rating is calculated
Reviews summary
Pros
- : Simple instructions make it easy to use.
- : Simple directions make it easy to use.
- : Provides reliable results when following instructions.
Generated by AI
Customer photos
- +7 images
Sort by |
Showing 1-3 of 98 reviews
May 21, 2025
Michelle
Top Reviewer
Item details
Count per pack: 1
5 out of 5 stars review
Verified Purchase
Great Product! Highly Recommend!!
Helpful?
reply from MoldArmorExpert
Sep 24, 2024
Kym
Top Reviewer
Item details
Size: 1
5 out of 5 stars review
Verified Purchase
Works great
Helpful?
Nov 7, 2024
Elle66
Item details
Size: 1
5 out of 5 stars review
Verified Purchase
Worked three out of three tests
Helpful?